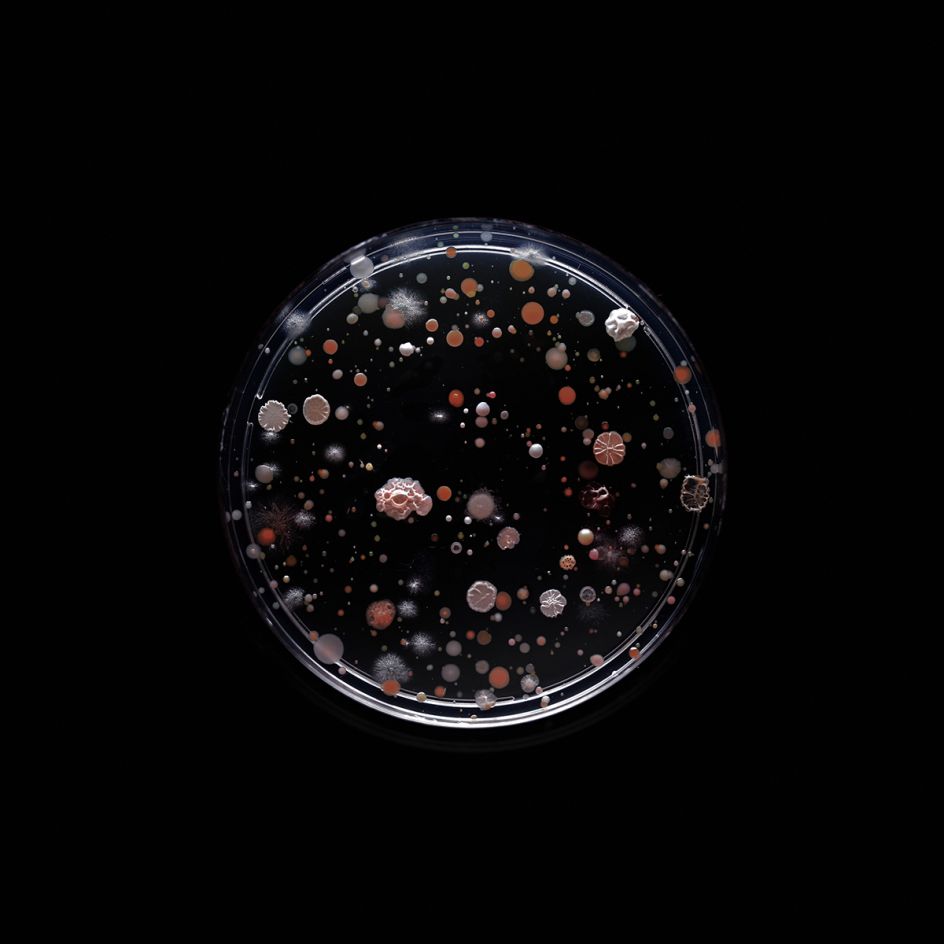

Photographer transforms bacteria found on the New York City subway into art
It's difficult to imagine the sheer amount of bacteria that we're exposed to each and every day. And when it comes to thinking about it, the majority of us are probably of the impression that it's not worth it.

One photographer however has made bacteria his business, documenting the germs that await the commuters of the New York City subway. In Subvisual Subway, Craig Ward explores the invisible world that exists on the handrails and seats of busy trains. And strangely, the results are rather beautiful.
Ward explains: "Over the summer of 2015, I rode the trains of each of New York City's twenty-two subway lines, collecting bacterial samples from hand rails, seats and other high traffic surfaces in an attempt to create an unconventional series of portraits of the city’s complex eco-system and a snapshot of the city at large.
"The samples were taken using sterilised sponges that had been pre-cut into the letter or number of the subway line from which the sample was to be taken - A, C, 1, 6 etc. The swabs were then pressed into pre-poured agar plates – their circular shape echoing the graphic language of the subway – incubated for up to a week in a Brooklyn workshop, and photographed at various stages of development before being safely neutralised and disposed of.
"The resulting images are a portrait of the complex microcosm that each of us contribute to and are a part of, and serve as an excellent visual analogy for diversity of the city at large. They hopefully also serve as a reminder that in a place that can make you feel extremely small, there are countless billions of smaller inhabitants."
For those interested in the contents of the petri dishes, Ward has broken down the different types of bacteria here. Who knew that germs could be so pretty?

](https://www.creativeboom.com/upload/articles/90/908fdb6378db1e95d12595416f54e6336d5e80b8_732.jpg)











